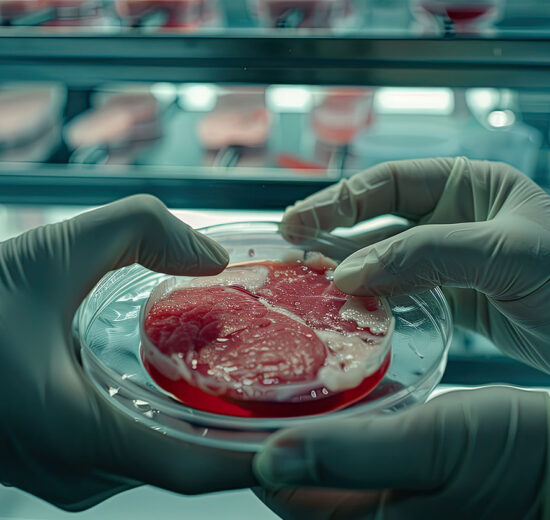

What’s up, second-gen squad? Forget avocado toast – Gen Z’s flipping the food game with lab-grown meat that’s never mooed or clucked. A June 2025...
Lab-Grown Meat: Gen Z Are Ready to Take a Bite Out of the Future

What’s up, second-gen squad? Forget avocado toast – Gen Z’s flipping the food game with lab-grown meat that’s never mooed or clucked. A June 2025...
Sorry, there are no posts found on this page. Feel free to contact website administrator regarding this issue.